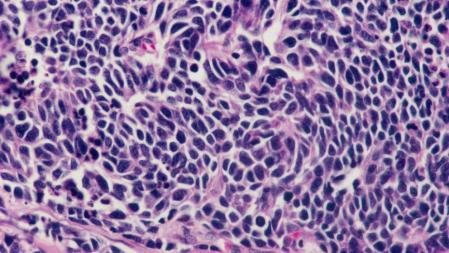
Células cancerígenas de pulmón.

Todos los seres vivos multicelulares del planeta pueden tener cáncer. Desde las plantas hasta los insectos, pasando por cualquier mamífero o ave. Sin embargo, hay especies que apenas sufren esta enfermedad. Es el caso del elefante. Los datos hablan por sí solos. Mientras la mortalidad del cáncer en seres humanos puede alcanzar al 25%, en los elefantes no llega al 5%. Los expertos definen esta excepción como "fascinante".
El porqué de esta increíble capacidad todavía es un misterio, pero ahora, un estudio internacional que ha contado con la participación del Instituto de Biotecnología y Biomedicina de la Universidad Autónoma de Barcelona (IBB-UAB) arroja un poco de luz sobre cómo estos mamíferos, los más grandes que pisan la Tierra, se protegen contra los tumores. La genética es un factor determinante.
La genética de los elefantes, un factor determinante

La genética de los elefantes, un factor determinante
A pesar de tener 100 veces más células que un ser humano y de ser muy longevos, rara vez los elefantes padecen cáncer. Ahora, un estudio internacional con participación del Instituto de Biotecnología y Biomedicina de la Universidad Autónoma de Barcelona (IBB-UAB) ha hallado en la génetica de estos animales la pista sobre por qué apenas sufren esta enfermedad.
El estudio, que publica la revista Molecular Biology and Evolution, ha identificado cómo se activan las 20 formas diferentes de la proteína p53 exclusivas de los elefantes para aumentar la sensibilidad y la respuesta contra las condiciones carcinógenas.
La investigación, según sus autores, supone un avance en la comprensión sobre cómo p53 contribuye a prevenir el desarrollo del cáncer y aporta una nueva perspectiva para estudiar la activación de esta proteína en humanos e investigar nuevas terapias. El trabajo lo han llevado a cabo científicos de siete instituciones, que han utilizado una modelización bioinformática pionera para investigar las interacciones moleculares de la proteína p53, conocida por proteger contra el cáncer.
Otros factores que aumentan las mutaciones de las células cancerígenas
Células cancerígenas de pulmón.
El estudio ha sido coordinado por Konstantinos Karakostis, investigador del grupo de Genómica Funcional y Comparativa del IBB, quien ha recordado que, además de la genética, existen factores como los compuestos tóxicos, estrés, malas condiciones de vida y envejecimiento que aumentan las mutaciones de las células y crece la posibilidad de que las proteínas que se replican puedan transcribir el ADN erróneamente y provocar cáncer.
El riesgo de los tumores resultantes de la acumulación de estas mutaciones genéticas aumenta con la edad, pero, a diferencia de los humanos, los elefantes parecen resistirse a esta tendencia. A pesar de su gran tamaño y una esperanza de vida comparable a la de los humanos, la mortalidad por cáncer en estos animales se estima que es inferior al 5 %, mientras que en humanos puede llegar al 25 %.
La mortalidad del cáncer en seres humanos puede llegar al 25%, en los elefantes no llega al 5%

La mortalidad del cáncer en seres humanos puede llegar al 25%, en los elefantes no llega al 5%
Los científicos relacionan la alta resistencia de los elefantes al cáncer con sus 20 copias del gen p53, que denominan el "guardián del genoma", en comparación con el único gen p53 de otros mamíferos. Según los investigadores, la proteína P53 desempeña un papel clave en la regulación de los mecanismos de reparación del ADN y suprime el crecimiento celular incontrolado.
Esta proteína se activa cuando se daña el ADN y ayuda a orquestar una respuesta que detiene la replicación del ADN y repara las copias no corregidas de la célula. En las células replicadas con ADN no dañado, la actividad de reparación de p53 es innecesaria y es inactivada por otra proteína, la ubiquitina ligasa MDM2 E3.
"La interacción regulada entre p53 y MDM2 es esencial para que las células sanas se dividan y repliquen, las dañadas se reparen y se destruyan las células con reparaciones fallidas o daños extensos", han señalado los investigadores.
"El elefante puede parecer genéticamente superdotado con 40 alelos, o versiones, de sus veinte genes p53, pero cada uno de estos alelos es estructuralmente ligeramente diferente, lo que da a este animal una gama mucho más amplia de interacciones moleculares contra el cáncer que un humano con sólo dos alelos de un solo gen", detallan.
Utilizando análisis bioquímicos y simulaciones informáticas, los investigadores han descubierto diferencias clave en la interacción regulada entre las diversas isoformas de p53 del elefante y la MDM2, lo que modifican significativamente su función. Así, han descubierto que, como resultado de los cambios en las secuencias de codificación y en la estructura molecular, varias p53 escapan a la interacción con MDM2, que normalmente provocaría su inactivación.



